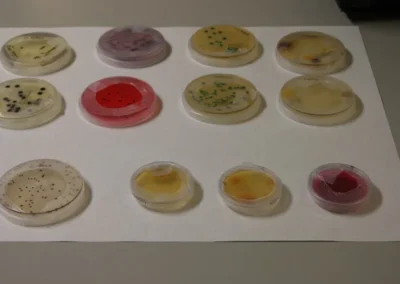
microbiológia aplicada 2014
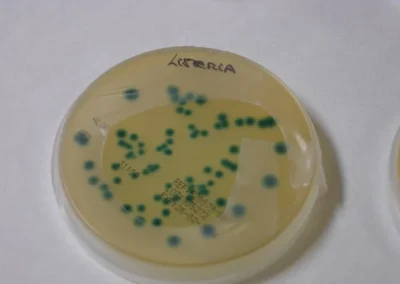
microbiológia aplicada 2014

Finaliza el curso de «microbiológia aplicada 2014»

El 6 de Marzo de 2014 ha finalizado el curso de microbiologia aplicada 2014 impartido por Laura Rodriguez (Técnico de Calidad y Seguridad alimentaria) y Eva Velasco (Responsable del Laboratorio del CETECE) en las instalaciones del CETECE Al curso asistieron 17 personas de diferentes sectores agroalimentarios y con formación superior diversa.El cursos contaba con una parte importante de prácticas, donde todos los alumnos pudieron participar activamente.
PRÓXIMOS CURSOS Y JORNADAS
¿Te interesan nuestros cursos y jornadas ? Te proporcionaremos las herramientas necesarias para destacar en esta industria dinámica y en constante evolución.
Noticias

Noticias

Ayudas a Empresas

Artículos

Cursos realizados

jornadas Realizadas

Ferias y Eventos

0 Comentarios